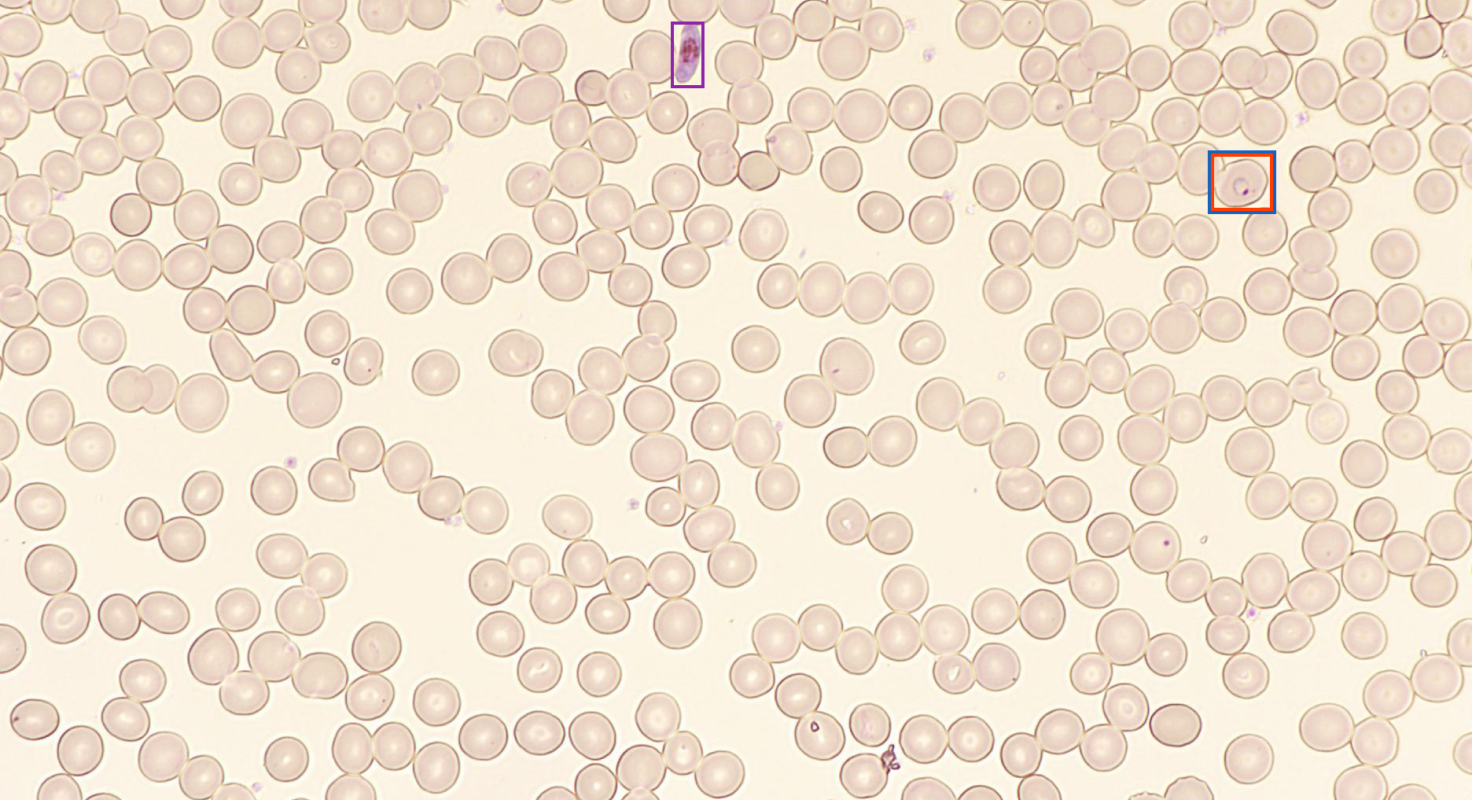

본 웹사이트는 사용자에게 최상의 사용자 경험을 제공하기 위해 쿠키를 사용합니다. 쿠키 정보는 브라우저에 저장되어 사용자가 당사 웹사이트로 돌아올 때 사용자를 인식하고, 사용자가 가장 흥미롭고 유용하다고 생각하는 웹사이트 섹션을 당사 팀이 파악하는 데 도움을 주는 등의 기능을 수행합니다.
탈중앙화 진단검사 플랫폼, 
마이랩
 Accessibility진단검사실의 정확성과 현장진단의 접근성을 
진단검사실의 정확성과 현장진단의 접근성을 
 모두 만족시킨 탈중앙화 솔루션
- 현업의 문제
 -  진단검사실은 진단 정확도는 높지만 운영비 부담이 높습니다. 
현장진단 중심의 신속검사는 접근성은 높지만 골드스탠다드 방식 구현에 한계가 있습니다. 

- 마이랩 효용
 -  마이랩은 진단검사의 정확도와 접근성 간 딜레마(Trade-off)를 해소했습니다. 
진단실험실이 갖춰지지 않은 의료기관에서도 정확한 진단 검사를 가능하게 합니다. 
 Workflow 노동집약적 진단검사 전과정의 자동화/디지털화로 
 노동집약적 진단검사 전과정의 자동화/디지털화로 
 효율성을 극적으로 높인 혁신적 솔루션
- 현업의 문제
 -  기존 현미경 진단검사는 전문 인력 숙련도에 따라 검사 결과와 검사 시간에 편차가 존재합니다. 
검체 보관과 이동에도 물리적인 시간과 자원이 소요됩니다. 

- 마이랩 효용
 -  전 과정의 자동화로 일관된 검사 결과 확보가 가능합니다. 
모든 결과가 디지털 정보로 공유 가능하여 진단검사 소요 시간을 획기적으로 단축할 수 있습니다. 
 Scalability
같은 장비에서 카트리지 교체만으로 다양한 질병 진단이 가능한 확장성 높은 솔루션
- 현업의 문제
 -  자원이 부족한 환경일수록 여러 종류의 진단검사 장비를 구매하기에는 비용 부담이 존재합니다. 
특히 일차보건시설에서는 이같은 비용 부담으로 진단 서비스 확장에 제약이 있습니다. 

- 마이랩 효용
 -  Romanowsky, Papanicolaou, H&E 등 다양한 염색법 적용이 가능합니다. 
한 대의 장비로 혈액, 세포, 조직 검체 대상 다양한 진단 검사로 확장할 수 있습니다. 
 Product Roadmap 감염질환, 혈액분석, 암진단, 암프로파일링 등 
 감염질환, 혈액분석, 암진단, 암프로파일링 등 
 정밀 진단 분야로 점차 확대되는 제품 포트폴리오
 혈액학 분야의 말라리아진단, 혈구형태분석 제품을 출시 후, 
 현재 자궁경부암, 유방암, 갑상선암 검사를 위한 카트리지 개발을 진행 중입니다. 
 또한, 암 프로파일링 분야의 다양한 암 정밀진단 제품 개발을 위한 선행 연구를 수행하고 있습니다.

원격 의료를 위한 디지털 진단서비스로의 확장성
원격 의료를 위한 당사의 Digital Lab 개념도- miLab 보급이 된 곳 어디에서나 지역과 환경의 제약 없이 양질의 진단 서비스 제공 가능
 - 진단 데이터 누적을 통한 AI 진단 서비스 가능
 

 Reference국제적으로 저명한 연구자들과 함께